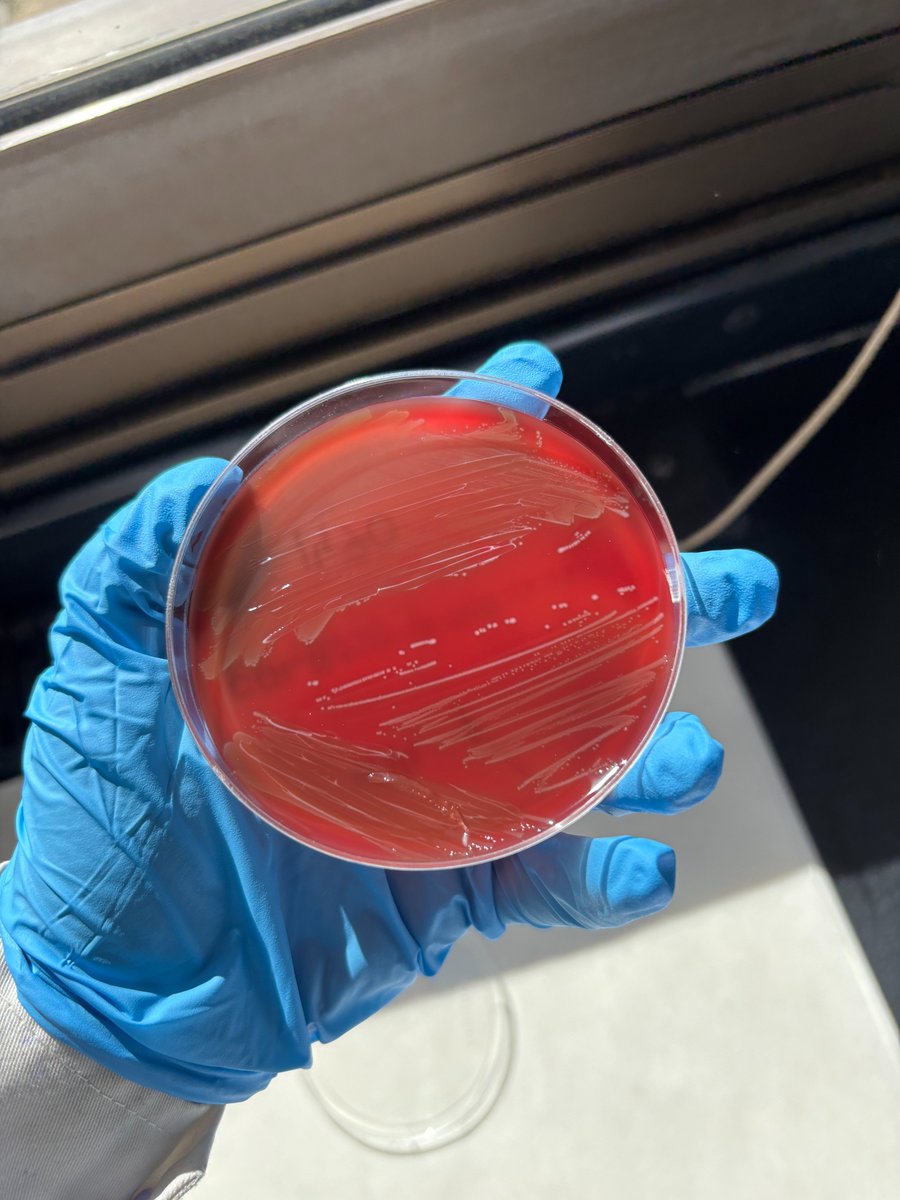
🧪🦠 Seguimos avanzando: Álvaro y Lucía (2.º BIE) han realizado en la ULE cultivos, antibiogramas y caracterización genética de los aislados de Streptococcus suis . 💊🧬
#BIE #somosBIEsomosCiencia #proyectoantibióticos #ieslossauces #benavente #unileon <a href="/sauces49000391/">IES LOS SAUCES</a> <a href="/unileon/">Universidad de León</a>

Rafael Pérez Romero
@rafa_perez_rom
ORCID ID
orcid.org/0000-0003-1639…
ID: 399556636
https://dptobiologiaieslossauces.blogspot.com/ 27-10-2011 17:40:38
1,1K Tweet
188 Followers
139 Following

🍯🔬 Nerea y María, del BIE1, investigan el origen y la calidad de las mieles de la comarca de Benavente y Los Valles a través de análisis polínico y organoléptico. 🐝🌼 #BIE #somosBIEsomosCiencia #proyectomieles #ieslossauces #benavente #unileon IES LOS SAUCES Universidad de León


🌦️📈 ¿Podemos predecir el clima del futuro si ni siquiera acertamos con el tiempo del fin de semana? ❄️🌍 #BIE #BIE1 #tallerfísica #meteorología #somosBIEsomosCiencia #ieslossauces #benavente #unileon ies los sauces @unileon_es


🔬🧫 En la asignatura de Iniciación a la Investigación del Bachillerato de Investigación/Excelencia, el laboratorio cobra vida.👩🔬👨🔬 #BIE #BIE1 #iniciaciónalainvestigación #biología #somosBIEsomosCiencia #ieslossauces #benavente IES LOS SAUCES


🌲🌿 ¡Explorando los ecosistemas mediterráneos en Villardeciervos! 🔍🏞️ #BIE #BIE1 #tallerbiología #ecología #somosBIEsomosCiencia #ieslossauces #benavente #unileon IES LOS SAUCES Universidad de León


🔬📈 El BIE sigue y mejora: de la promoción 2024/25 a la 2025/26: grupos sanguíneos (🩸) e investigación de hongos (🍄). #BIE #BIE1 #iniciaciónalainvestigación #grupossanguíneos #hongos #somosBIEsomosCiencia #ieslossauces #benavente #unileon IES LOS SAUCES Universidad de León


🍔🔬🚀 ¡Primer taller universitario del curso 2025/2026! - “Identificación de compuestos ‘extraños’ en alimentos”🧪🔍 #BIE #BIE1 #tallerquímica #aditivos #somosBIEsomosCiencia #ieslossauces #benavente #unileon IES LOS SAUCES Universidad de León


🧪🦠💊 Álvaro y Lucía (2.º BIE) han realizado en la ULE el análisis de aislados de Streptococcus suis, determinando su perfil de resistencia a antibióticos #BIE #somosBIEsomosCiencia #proyectoantibióticos #ieslossauces #benavente #unileon IES LOS SAUCES Universidad de León


🍄📡 “La WiFi de la naturaleza”: el alumnado de 1.º BIE del IES Los Sauces investiga las micorrizas en la Universidad de León. 🌱🔬 #BIE #BIE1 #tallerbiología #micorrizas #somosBIEsomosCiencia #ieslossauces #benavente #unileon IES LOS SAUCES Universidad de León


“La WiFi de la naturaleza” youtu.be/kMt5LpzPyi0?si… vía YouTube 🍄📡 “La WiFi de la naturaleza” 🌱🔬 #BIE #BIE1 #tallerbiología #micorrizas #somosBIEsomosCiencia #ieslossauces #benavente #unileon IES LOS SAUCES Universidad de León

🧫🔬 Celia, Úrsula y Lidia (2.º BIE) han trabajado en la ULE en el proyecto “Cultivo y congelación de células mesenquimales del tejido adiposo” ❄️ #BIE #somosBIEsomosCiencia #proyectocultivocélulas #ieslossauces #benavente #unileon IES LOS SAUCES Universidad de León


🌼🔬🌬️ En la ULE, el alumnado de 1.º BIE participa en el taller “La alergia al polen y la botánica: una relación que no esperabas”. 📈 #BIE #BIE1 #tallerbiología #polen #somosBIEsomosCiencia #ieslossauces #benavente #unileon IES LOS SAUCES Universidad de León


Proyecto cultivos celulares - BIE IES Los Sauces youtu.be/XyqLaVrUwHg?si… a través de YouTube #BIE #somosBIEsomosCiencia #proyectocultivocélulas #ieslossauces #benavente #unileon Universidad de León IES LOS SAUCES

🍯🔬🐝 Nerea y María (2.º BIE) continúan su proyecto de mieles: en el laboratorio de la ULE han identificado los distintos tipos polínicos de las muestras. 🌼 #BIE #somosBIEsomosCiencia #proyectomieles #ieslossauces #benavente #unileon IES LOS SAUCES Universidad de León


“La alergia al polen y la botánica: una relación que no esperabas” youtu.be/9dNCT2l9pOM?si… vía YouTube IES LOS SAUCES Universidad de León 🌼🔬🌬️ En la ULE, el alumnado de 1.º BIE participa en el taller del polen 📈 #BIE #BIE1 #tallerbiología #polen #somosBIEsomosCiencia #ieslossauces

🌿📱🤖 Aplicaciones de IA para la identificación de plantas 🌱🔍 #BIE #somosBIEsomosCiencia #proyectobotánica #ieslossauces #benavente #unileon IES LOS SAUCES Universidad de León


💧🧪 En la ULE, el alumnado de 1.º BIE investiga “¿Es agua todo lo que bebemos?” Ciencia útil para el día a día. 🔍🥤 #BIE #BIE1 #tallerquímica #agua #somosBIEsomosCiencia #ieslossauces #benavente #unileon IES LOS SAUCES Universidad de León

🍯🔬🐝 Nerea y María (2.º BIE), en el laboratorio del IES Los Sauces, han observado al microscopio e identificado los distintos tipos polínicos de las muestras. 🌼🧪 #BIE #somosBIEsomosCiencia #proyectomieles #ieslossauces #benavente #unileon IES LOS SAUCES Universidad de León


🧪🦠 Seguimos avanzando: Álvaro y Lucía (2.º BIE) han realizado en la ULE cultivos, antibiogramas y caracterización genética de los aislados de Streptococcus suis . 💊🧬 #BIE #somosBIEsomosCiencia #proyectoantibióticos #ieslossauces #benavente #unileon IES LOS SAUCES Universidad de León